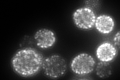
YGR086C
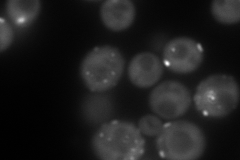
YGR086C
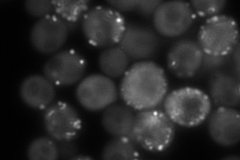
YGR086C
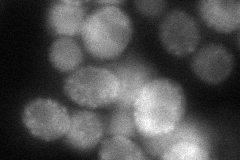
YGR086C

View description
Primary component of eisosomes, which are large immobile cell cortex structures associated with endocytosis; null mutants show activation of Pkc1p/Ypk1p stress resistance pathways; detected in phosphorylated state in mitochondria
Localization:
Intensity:
Fold change:
Significance:
-
C’ GFP library in SD
punctate395.69 -
N' NOP1pr-GFP in SD
cytosol,punctate256.981 -
N' TEF2pr-mCherry in SD

cytosol,punctate392.129 -
N' NATIVEpr-GFP in SD
cell periphery,punctate293.939 -
N' TEF2pr-VC and Cyto-VN in SD
cytosol,punctate74.9139 -
C’ GFP library in SD+DTT

punctate606.51.53Yes -
C’ GFP library in SD+H2O2

punctate451.631.14No -
C’ GFP library in Starvation Media

punctate826.142.08Yes -
C’ GFP library on the background of Pup2-DaMP

N/A -
C’ GFP library on the background of CCT mutant

N/A0N/AYes
